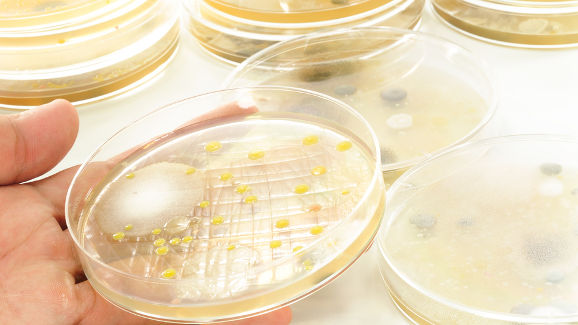
Onemogočanje tvorbe biofilma

NEWCASTLE UPON TYNE – Biofilmi so pomemben problem v skrbi za dentalno in telesno zdravje, saj tvorijo zobni plak, vzdržujejo kronični rinosinuzitis in povzročajo akutne eksacerbacije kroničnega rinosinuzitisa ter so vzrok resnim okužbam telesnih vsadkov. Znanstveniki raziskujejo molekularno podlago tvorbe biofilma, da bi identificirali primerno tarčo za onemogočanje nastanka biofilma.
Raziskovalci z Univerzitetnega inštituta za celično in molekularno biologijo iz Newcastla so opazovali tvorbo biofilma bakterij Bacillus subtilis, ki so modelni organizem za laboratorijske raziskave, da bi se dokopali do novih spoznanj o pričetku nastanka biofilma.
Z radiokristalografijo so ugotovili, da DNA-vezavni protein (transkripcijski faktor) SinR funkcionira kot glavni regulator formiranja biofilma, saj je odgovorne za prehod B. subtilis iz prostoživeče (planktonske) oblike v konformacijo biofilma. Do spoznanja so prišli s pomočjo inhibicije ekspresije proteinov, potrebnih za sintezo intercelularnega matriksa, ki ohranja tridimenzionalno konformacijo bakterij kot nekkšno lepilo.
Strukturna analiza transkripcijskega faktorja SinR je pripomogla tudi k iskanju njegovih antagonistov, ki bi onemogočali njegovo delovanje. Znanstveniki upajo, da bodo nova spoznanja vodila v razvoj učinkovitih strategij v boju proti tvorbi biofilma.
Raziskava “Molecular basis of activity of SinR protein, the master regulator of biofilm formation in Bacillus subtilis” je bila objavljena v aprilski izdaji Journal of Biological Chemistry.
SALÉ, Maroko: Zaskrbljenost glede potencialne citotoksičnosti in okoljskega vpliva običajnih irigantov koreninskih kanalov je spodbudila raziskovanje ...
Kombinacija 0,12% klorheksidin diglukonata in Alpante (alantoin pantenola) je učinkovito sredstvo in koadjuvans pri večini parodontalnih bolezni in ...
Webinar v živo
pon. 6 julij 2026
6:00 (CET) Ljubljana
Webinar v živo
sre. 8 julij 2026
2:00 (CET) Ljubljana
Dr. Mark Donaldson BSP, ACPR, PHARMD, FASHP, FACHE
Webinar v živo
sre. 8 julij 2026
2:00 (CET) Ljubljana
Webinar v živo
sre. 8 julij 2026
7:00 (CET) Ljubljana
Prof. Gianluca Gambarini MD, DDS
Webinar v živo
čet. 9 julij 2026
4:00 (CET) Ljubljana
Dr. Jae Seon Kim DDS, MSD, FACP, CDT
Webinar v živo
čet. 9 julij 2026
7:00 (CET) Ljubljana
Dr. Armando Lopes, Dr. Carlos Moura Guedes
Webinar v živo
pet. 10 julij 2026
2:00 (CET) Ljubljana



 Avstrija / Österreich
Avstrija / Österreich
 Bosna in Hercegovina / Босна и Херцеговина
Bosna in Hercegovina / Босна и Херцеговина
 Bolgarija / България
Bolgarija / България
 Hrvaška / Hrvatska
Hrvaška / Hrvatska
 Češka & Slovaška / Česká republika & Slovensko
Češka & Slovaška / Česká republika & Slovensko
 Francija / France
Francija / France
 Nemčija / Deutschland
Nemčija / Deutschland
 Grčija / ΕΛΛΑΔΑ
Grčija / ΕΛΛΑΔΑ
 Madžarska / Hungary
Madžarska / Hungary
 Italija / Italia
Italija / Italia
 Nizozemska / Nederland
Nizozemska / Nederland
 Nordijska / Nordic
Nordijska / Nordic
 Poljska / Polska
Poljska / Polska
 Portugalska / Portugal
Portugalska / Portugal
 Romunija & Moldavija / România & Moldova
Romunija & Moldavija / România & Moldova
 Slovenija / Slovenija
Slovenija / Slovenija
 Srbija & Črna gora / Србија и Црна Гора
Srbija & Črna gora / Србија и Црна Гора
 Španija / España
Španija / España
 Švica / Schweiz
Švica / Schweiz
 Turčija / Türkiye
Turčija / Türkiye
 Velika Britanija in Irska / UK & Ireland
Velika Britanija in Irska / UK & Ireland
 Mednarodno / International
Mednarodno / International
 Brazilija / Brasil
Brazilija / Brasil
 Kanada / Canada
Kanada / Canada
 Latinska Amerika / Latinoamérica
Latinska Amerika / Latinoamérica
 ZDA / USA
ZDA / USA
 Kitajska / 中国
Kitajska / 中国
 Indija / भारत गणराज्य
Indija / भारत गणराज्य
 Pakistan / Pākistān
Pakistan / Pākistān
 Vietnam / Việt Nam
Vietnam / Việt Nam
 ASEAN / ASEAN
ASEAN / ASEAN
 Izrael / מְדִינַת יִשְׂרָאֵל
Izrael / מְדִינַת יִשְׂרָאֵל
 Alžirija, Maroko in Tunizija / الجزائر والمغرب وتونس
Alžirija, Maroko in Tunizija / الجزائر والمغرب وتونس
 Srednji vzhod / Middle East
Srednji vzhod / Middle East

To post a reply please login or register